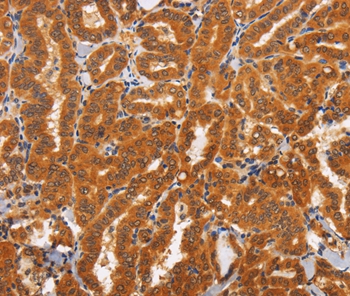

CD30 Antibody (Extracellular Domain, FITC)
LS-C13243
ApplicationsFunctional Assay, Flow Cytometry
Product group Antibodies
TargetTNFRSF8
Overview
- SupplierLifeSpan BioSciences
- Product NameCD30 Antibody (Extracellular Domain, FITC)
- Delivery Days Customer23
- Application Supplier NoteFlow cytometry. In vitro functional studies. Flow Cytometry: 3 ug/1E6 cells. The applications listed have been tested for the unconjugated form of this product. Other forms have not been tested.
- ApplicationsFunctional Assay, Flow Cytometry
- Applications SupplierFlo, Func Flow cytometry. In vitro functional studies. Flow Cytometry: 3 ug/1E6 cells. The applications listed have been tested for the unconjugated form of this product. Other forms have not been tested.
- CertificationResearch Use Only
- ClonalityMonoclonal
- ConjugateFITC
- Estimated Purity...
- Gene ID943
- Target nameTNFRSF8
- Target descriptionTNF receptor superfamily member 8
- Target synonymsCD30; CD30L receptor; cytokine receptor CD30; D1S166E; Ki-1; Ki-1 antigen; lymphocyte activation antigen CD30; tumor necrosis factor receptor superfamily member 8
- HostHamster
- IsotypeIgG
- Storage Instruction-20°C,2°C to 8°C
- UNSPSC12352203